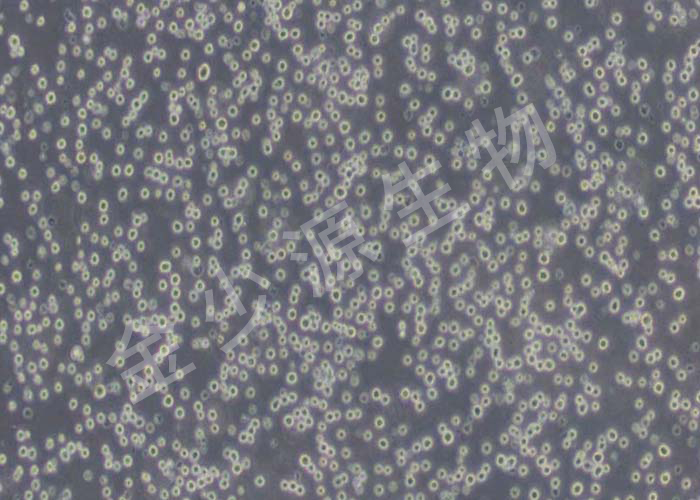

金少源生物技术员工们具备创新的学术背景,特别在细胞培养方面经验丰富
金少源(上海)生物科技有限公司是一家集产品科研、生产、销售为一体的专业化生物工 程公司。公司具有完善的实验技术开发平台,成熟的抗原、抗体研发系统,熟练掌握各种酶联技术,结合公司的研发团队,可以有的保证公司产品强的稳定性和高的准确性,同时又具有竞争力的价格。公司目前可以提供生化试剂、分子生物学试剂及试剂盒,各种抗体及免疫学试剂盒、实验耗材等多门类上万种产品,产品涉及分子生物学、细胞生物学、免疫学等生命科学的各个领域。
产品在相当宽的领域得到广泛的应用,长期和各大高校、研究机构、工厂、企业等建广泛的应用,长期和各大高校、研究机构、工厂、企业等建立了深厚的合作,我们的企业文化是为树立行业的地位而不懈努力,为科研事业贡献绵薄之力!公司的产品价值,位而不懈努力,为科研事业贡献绵薄之 力!公司的核心价值是诚信为本,质量优良,为客户提供创新的产品、为员工提供发展平台、为社会创造更多价值。
公司细胞技术人员拥有近二十年不同基质的基球开发和官能化的丰富技术经验,对琼脂糖、葡聚糖以及高分子聚合物等系列分离介质的开发生产与应用具有创新的优势,不仅对常规成熟产品品系可与行业内企业快速对标,而且对生物医药领域的新兴技术做了前瞻性的产品科研。


行业质量标准ISO9001
众多权威专利认证

10多年细胞培养经验
专业技术实力保障

拥有自己的科研基地
规范准确性行业创新水平

我们拥有温馨的呵护
享受四大贴心服务
自主研发生产 探索多个领域

细胞培养是生物医学研究人员必须掌握的一项基本技能,是实验成功与否的关键。所以,了解细胞培养的基本操作要领,对生物医药...

原代培养及其操作步骤 原代分离细胞培养是指从供体内取出组织后,经机械以及消化分离成单个细胞或单一型细胞群,使之...

细胞是生命的基本单位,其可以分为原代细胞和传代细胞。这两种细胞之间存在着一些相似和不同之处,本文将介绍原代细胞和传代细胞...